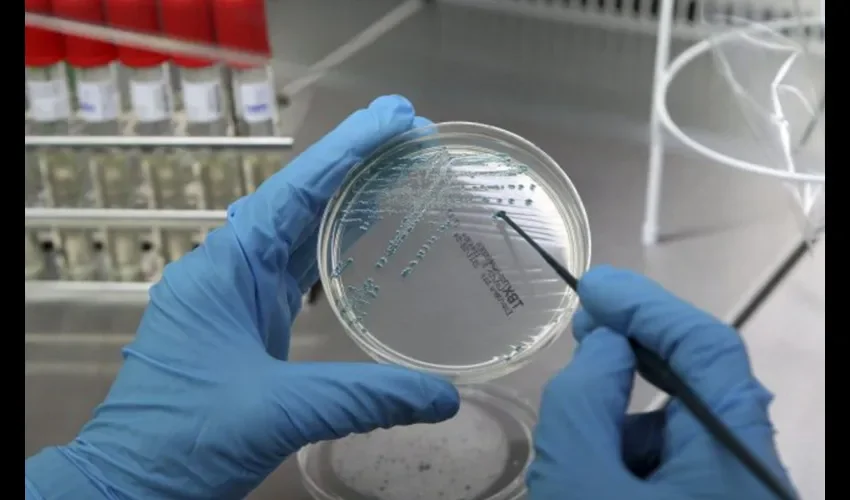

La Cámara de la Comunes británica dio luz verde a la técnica que utiliza el ADN de tres personas en la reproducción asistida, a fin de evitar la transmisión de enfermedades genéticas.
Los diputados aprobaron esta técnica, denominada donación mitocondrial, por amplia mayoría, con 382 votos a favor frente a 128 en contra.
Si prospera la legislación, que pasará ahora a la Cámara de los Lores, el Reino Unido se convertirá en el primer país del mundo que legaliza la reproducción asistida con genes de tres individuos.
Aunque el Gobierno británico ha dado su respaldo al procedimiento, los diputados pudieron ejercer el voto libre, sin someterse a la disciplina de su partido, por tratarse de un tema muy sensible.
Los científicos estiman que alrededor de 2,500 mujeres en el Reino Unido podrían beneficiarse de este procedimiento, que cuenta con el apoyo de científicos de todo el mundo.